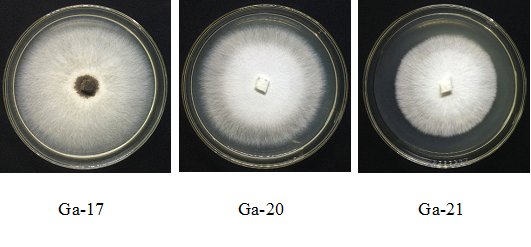

Từ những năm 2000 trở lại đây việc nghiên cứu vê nấm lớn, đặc biệt là nấm dược liệu cũng được các nhà Khoa học Việt Nam quan tâm và có kết quả đáng kể. Một trong những nghiên cứu đầu tiên về thành phần và hoạt chất sinh học của nấm Linh chi ở Việt Nam được nhóm tác giả Nguyễn Thị Chính và cs (2005) nghiên cứu. Kết quả cho thấy loài Linh chi Ganoderma lucidum nuôi trồng ở Việt Nam có đầy đủ các thành phần như protein, đường, lipit, muối khoáng, vitamin C với hàm lượng cao, 1-3-β-D- glucan đạt 36%, có thể đưa vào điều trị khối u, ung thư, có khả năng sửa chữa phần nào gen bị hư hỏng.
Loài nấm linh chi đen - Amauroderma subresinosum (Murr.) Coener cũng hiếm gặp, được phát hiện lần đầu ở vườn Quốc gia Cát Tiên vào cuối mùa mưa năm 2004, có nhiều nét phân hóa như những dạng trung gian giữa hai chi: Ganoderma và Amauroderma (Lê Xuân Thám và cs., 2009). Amauroderma subresinosum khi non, hình quạt khi trưởng thành, (hình thái thay đổi nhiều), kích thước 3-4x5-8x0,6-1,3cm. Mặt trên màu màu đen, bóng loáng, có tia phóng xạ, có vòng đồng tâm không quy luật, hơi nhăn nheo. Mặt dưới lỗ có màu trắng khi non, trắng hồng rồi chuyển sang nâu hồng khi trưởng thành, 3-4 l/mm. Ống trắng xám, trắng hồng, dày 10-15 mm, mô màu trắng, đôi khi nâu hồng.Mép nguyên, dày (xếp nếp), cũng có khi mỏng (cuộn không quy luật), men xuống phần ống, cómàu đen. Bào tử hình trứng gần bầu dục, màu vàng nhạt, kích thước 9,0-12,0x14,0-18,0 µm,màng 2 lớp: ngoài vàng nhạt, trong nâu nhạt (Trần Thị Phú và Trịnh Tam Kiệt., 2017).
Tại thị trường Việt Nam, nhu cầu sử dụng nấm Linh chi làm thuốc chữa bệnh ở trong nước cũng như xuất khẩu ngày càng tăng. Tuy nhiên, cho đến nay các chủng giống đang được nuôi trồng phổ biến ở Việt Nam chủ yếu các chủng nấm Hồng chi. Bên cạnh đó các chủng nấm Hắc chi mới chỉ được khai thác tự nhiên và chưa được nghiên cứu nhiều về công nghệ nhân giống cũng như nuôi trồng trong điều kiện nhân tạo. Tại Học viện Nông nghiệp Việt Nam đang lưu giữ 03 chủng nấm Hắc chi tự nhiên và bước đầu đánh giá khả năng sinh trưởng, phát triển trên môi trường nhân giống và nuôi trồng nhân tạo. Kết quả nghiên cứu đã thu được một số tín hiệu khả quan về sự thích nghi cũng như khả năng tạo quả thể trên môi trường nuôi trồng tổng hợp.
Trên môi trường nhân giống cấp 1 cả 3 chủng nấm Hắc chi sinh trưởng và phát triển khá ổn định, hệ sợi mượt và đều. Cả 3 chủng nấm Hắc chi đều sinh trưởng, phát triển được từ 15oC đến dưới 35oC và tốt nhất ở 25oC và 30oC.
Hệ sợi của cả 3 chủng nấm Hắc chi trong thí nghiệm đều phát triển đồng đều, ổn định trên môi trường nhân giống cấp 2 (giống thương phẩm) dạng xốp và thời gian sinh trưởng hệ sợi trên môi trường cấp 2 thể xốp khoảng 16-24 ngày tuỳ theo các chủng nấm khác nhau.
Khi tiến hành đánh giá khả năng sinh trưởng hệ sợi, hình thành quả thể của cả 03 chủng nấm Hắc chi tự nhiên trên giá thể nuôi trồng nhân tạo chúng tôi cũng đã thu được quả thể của 03 chủng nấm Hắc chi này kết.
    |
|
| Hình 1. Hệ sợi của 03 chủng nấm Hắc chi trên môi trường nhân giống cấp 1 |
    |
 |
| Hình 2. Hệ sợi của 03 chủng nấm Hắc chi trên môi trường nhân giống cấp 3. |
    |
 |
| Hình 3. Hình ảnh quả thể của 03 chủng nấm Hắc chi trên môi trường nuôi trồng nhân tạo |
Tác giả: Nguyễn Thị Luyện, Ngô Xuân Nghiễn, Nguyễn Thị Bích Thuỳ, Trần Đông Anh, Nguyễn Thị Huyền Trang.